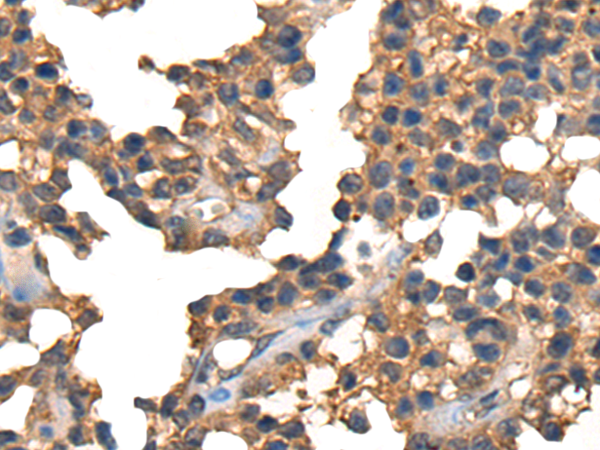

|
Background: |
This gene is a member of the immunoglobulin superfamily and encodes a protein which transmits an inhibitory signal to T cells. The protein contains a V domain, a transmembrane domain, and a cytoplasmic tail. Alternate transcriptional splice variants, encoding different isoforms, have been characterized. The membrane-bound isoform functions as a homodimer interconnected by a disulfide bond, while the soluble isoform functions as a monomer. Mutations in this gene have been associated with insulin-dependent diabetes mellitus, Graves disease, Hashimoto thyroiditis, celiac disease, systemic lupus erythematosus, thyroid-associated orbitopathy, and other autoimmune diseases. |
|
Applications: |
ELISA, IHC |
|
Name of antibody: |
CTLA4 |
|
Immunogen: |
Synthetic peptide of human CTLA4 |
|
Full name: |
cytotoxic T-lymphocyte associated protein 4 |
|
Synonyms: |
CD; GSE; GRD4; ALPS5; CD152; CTLA-4; IDDM12; CELIAC3 |
|
SwissProt: |
P16410 |
|
ELISA Recommended dilution: |
5000-10000 |
|
IHC positive control: |
Human liver cancer and Human ovarian cancer |
|
IHC Recommend dilution: |
25-100 |

購(gòu)物車
購(gòu)物車 幫助
幫助
 021-54845833/15800441009
021-54845833/15800441009
